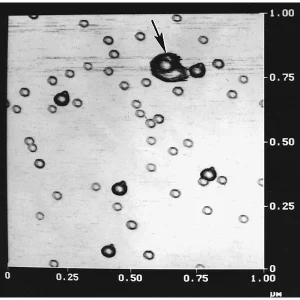
AFM Gold Calibration Kit

Products
AFM Calibration
- Apertures
- Apertures 1,85 x 0,1mm
- Apertures 2,0 x 0,1mm
- Apertures 2,0 x 0,25mm
- Apertures 2,0 x 0,6mm
- Apertures 3,0 x 0,1mm
- Apertures 3,0 x 0,25mm
- Apertures 3,04 x 0,25mm
- Apertures 4,0 x 0,2mm
- Apertures 4,0 x 0,6mm
- Apertures 6.35 x 0.02mm
- Apertures 6,35 x 0,125mm
- Apertures 10,0 x 0,1mm
- Apertures 10,0 x 0,6mm
- Apertures 12,0 x 0,1mm
- Apertures 19,99 x 0,25mm
- Gilded strip apertures
- Multihole Strip Apertures
- Spray Apertures
- Thin Foil Apertures
- Tantalum Wehnelt
- Top Hat Apertures
- Aperture Cleaning
- Brushes
- Calibration
- GSR & Particle Analysis
- Light Microscopy
- SEM Calibration
- (CD) Calibration Test
- Back Scattered Electron Test
- Boron substrates
- Chessy test specimen
- Critical Dimension Magnification Standards
- Demonstration Specimens
- Glass size standards
- Gold on Carbon
- Gold Spheres on Carbon
- Line/Grid Standards
- Low & Medium Magnification
- MRS-3
- MRS-4
- MRS-6
- Multi Calibration Standard
- Polystyrene Spheres
- Silicon test specimen
- Tin on Carbon
- TEM Calibration
- Chemicals
- Cleaning
- Cryo Products
- Desiccators Cabinets
- Diamond Knives
- Dissection
- Embedding
- FIB Supplies
- Filaments
- Forensics
- General Lab Supplies
- Applicator, Sticks and Swabs
- Beakers, Cylinders and Containers
- Cell Strainer System
- Dishes and Boats
- Glass Bottom Dishes
- Laboratory Glassware
- Laboratory Tongs
- Microscopy Illuminators
- Microwave Specimen Holders
- Parafilm M®, Melinex Film
- PELCO Rotators
- Petri Dishes
- Pocket Scales
- Spatulas & Spoons
- Storage Jars, Containers & Bottles
- Thermometers
- Timers
- Ultraviolet Lamps
- Vials, Tubes and Cups
- Wire Mesh
- Gloves
- Grids
- Histology
- Immersion Oils
- Laboratory Tape
- Microscope Slides
- Pipettes and Pipettors
- PTFE Laboratory Products
- Razor- Microtome Blades
- Safety Products
- Slide Boxes, Trays & Mailers
- Slide Labels
- Spatulas and Spoons
- Staining
- Weighing Dishes
- Carbon tabs, tapes & sheets
- Mount Storage Boxes
- Planchets
- Replication Materials
- Scintillators
- Specimen Mount Grippers
- Specimen Preparation Stations
- Starter Kits
- Stubs, Mounts and Holders
- M4 Threaded, Cylinder, and Other Stubs
- Bulk Specimen Holders, M4
- Carbon Planchet Holders, M4
- Carbon, Brass, and Copper Mounts
- Cross Section Holders
- Cylinder Specimen Mounts
- E-Beam Lithography Mount, M4
- EBSD Pre-tilt Holders & Mounts, M4
- Filter Holders, M4
- Flat Sample Clip Holders
- Hitachi T-base Specimen Holders
- Metallographic Mount Holders
- Modular Stage Adapters, M4
- Mount Adapters, M4
- Multipurpose Specimen Holder
- Pin Stub Holders, M4
- Q Pin Mounts and Holders
- Rectangular Mounts
- SEMClamp Holders, M4
- SEMClip Cylinder Mounts
- SEMClip Geological
- STEM Imaging Holder, M4
- TEM Grid Holder, M4
- Tilt Specimen Holders
- Vise Type Holders
- Wafer & Large Sample Holders
- Pin Stubs Specimen Mounts and Holders
- Adapter Buttons
- Angled Pin Stub Holders
- Bulk Specimen Holders with Pin
- Carbon, Brass, and Copper, SEM Mounts
- E-Beam Lithography Mount
- EBSD Pre-tilt Holders & Mounts
- FIB Grid Holders
- Filter Holders, Pin
- Jeol Specimen Holders
- Low Profile FIB Mounts
- Low Profile SEMClip
- Metallographic Mount Holders
- Modular Stage Adapters
- Mount Adapters
- Multi Purpose / Bulk Holders
- Multi-Pin Stub Holders
- Pin Stub Specimen mounts
- Planchet Holders
- Q Pin Stubs and Holders
- Sample Holder Sets
- SEMClamp Holders
- SEMClip Pin Mounts
- Slotted Pin Stubs
- STEM Imaging Holder
- TEM Grid Holders
- Thin Section Holders
- Variable Tilt Holders
- Vise Clamp Holders
- Wafer Holders with Pin
- M4 Threaded, Cylinder, and Other Stubs
- Cabinets for Tissue Cassettes
- Cardboard, Tin Boxes & Cans
- Gel-Pak® Substrate Carriers
- Grid Storage Boxes
- Compact Modular Cabinet
- Plastic Jars, Containers & Bottles
- Membrane Boxes
- Plastic Storage Boxes
- Slide Boxes, Trays and Mailers
- Mount Storage Boxes
- Wafer Carrier Trays
- PELCO X-TREME Cases
- Zipper, Barrier Bags
- Accessories
- Aesculap® – Forceps
- Aquarius Tweezers
- Cantilever Tweezers
- Carbon Fibre tweezers
- Dumont™ Tweezers
- General Purpose Forceps
- Industrial, Economy Tweezers
- Mount Grippers
- PELCO Tweezers
- Plastic Tipped ESD Tweezers
- Plastic Tweezers, Flat & Sharp
- Plastic, Wafer Tip Styles
- Surgical Tissue Forceps
- Wafer Tweezers
- Wafer, Component, Cover Glass
- Wire Cutting Tweezers
- Zirconia Ceramic Tweezers